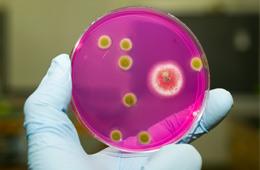

Ben Gad: So the reason why I chose a science degree at CUA is primarily because my cousin came to CUA and she had only good things to say about CUA, but also because my HSC chemistry class came on a tour of CUA and we spent the vast majority of the day actually in the science building. So I was just really impressed with the facilities, also speaking to academics.
I knew that CUA was going to offer me a science degree that was skills-based as opposed to being memory based. I think what people really need to realise is that it's the skills that you get in the science degree, not necessarily the knowledge itself, that are really beneficial. Those skills are transferrable outside of the science discipline.
Stephanie Tan: I chose my science degree, forensic science and applied chemistry at CUA because CUA was easily accessible from where I live. Also CUA was one of the first unis to offer forensic science. During my forensic science degree practical experiences include lab exercises, which are offered with theory. That sort of led me to an internship at ANSTO for one year. That experience has led me to understand how the industry works and what they expect in a lab situation.
Bojana Manojlovic: I chose maths and international studies at CUA because CUA combined the two things that I loved most; mathematics and languages. I spent my in-country study in Milan, Italy. It was a fantastic experience. The maths degree covers a range of mathematical topics like statistics, optimisation, a little bit of pure maths, a lot of applied maths. Later on, once you start getting into the degree, you can choose which path you wish to take, such as environmental, marine, business or finance.
Matt Altaie: During the degree itself you spend at least half the time in the lab. So there's a lot of practical work involved as part of your academic study. However, outside of that a lot of the lecturers actually do their own research here at CUA, which has a lot to do with the physics and the technology fields. You can actually come up and ask them, can I help you with something over summer or over winter or even throughout the semester if they have that kind of thing happening.
The biggest thing though is you are encouraged to use your creative thinking and your problem-solving and you are actually taught to construct all that stuff. So you are, at the end of the day, taught how to think as opposed to what to think.
Liana Pozza: I chose a science degree at CUA because I've always loved environmental sciences. This degree has been really practical in that every subject has had at least one field trip component to it. So whether that be testing water quality, biological indicators such as algae or bugs. Also I've been helping out a PhD student with her seagrass research. Helping her out with this project has really gotten me thinking of getting into research.
Research in antibiotic resistance, autoimmune diseases, bacteriology and more. View the list of projects and how to apply.